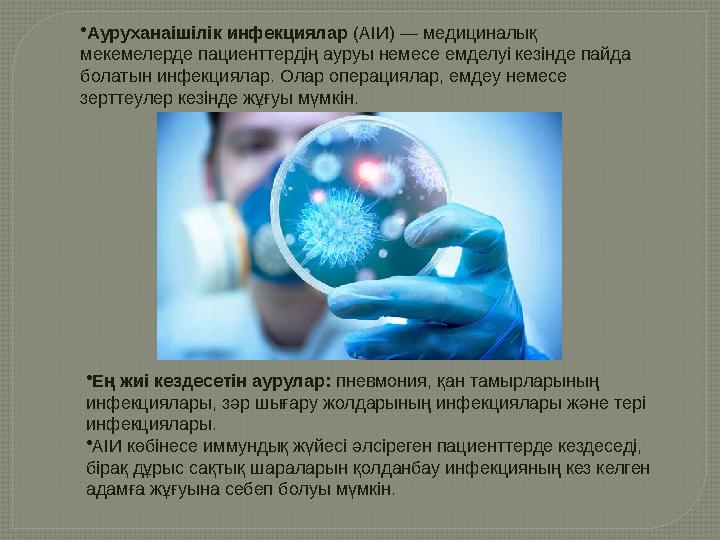
•Ауруханаішілік инфекциялар (АІИ) — медициналық мекемелерде пациенттердің ауруы немесе емделуі кезінде пайда болатын инфекци

Аурухана ішелік инфекция


#1 слайд
«Ауруханаішілік
инфекциялардың жуғу
жолдары»
1 слайд
«Ауруханаішілік инфекциялардың жуғу жолдары»

#2 слайд
1.Кіріспе
2.Ауруханаішілік
инфекциялар дегеніміз не?
3.Ауруханаішілік
инфекциялардың жұғу
жолдары
4.АІИ жұғуына себепші
факторлар
5.Жұғу жолдары мен аурулар
6.Ауруханаішілік
инфекциялардың алдын алу
шаралары
7.Қорытынды
2 слайд
1.Кіріспе 2.Ауруханаішілік инфекциялар дегеніміз не? 3.Ауруханаішілік инфекциялардың жұғу жолдары 4.АІИ жұғуына себепші факторлар 5.Жұғу жолдары мен аурулар 6.Ауруханаішілік инфекциялардың алдын алу шаралары 7.Қорытынды
#3 слайд
•Ауруханаішілік инфекциялар (АІИ) — медициналық
мекемелерде пациенттердің ауруы немесе емделуі кезінде пайда
болатын инфекциялар. Олар операциялар, емдеу немесе
зерттеулер кезінде жұғуы мүмкін.
•Ең жиі кездесетін аурулар: пневмония, қан тамырларының
инфекциялары, зәр шығару жолдарының инфекциялары және тері
инфекциялары.
•АІИ көбінесе иммундық жүйесі әлсіреген пациенттерде кездеседі,
бірақ дұрыс сақтық шараларын қолданбау инфекцияның кез келген
адамға жұғуына себеп болуы мүмкін.
3 слайд
•Ауруханаішілік инфекциялар (АІИ) — медициналық мекемелерде пациенттердің ауруы немесе емделуі кезінде пайда болатын инфекциялар. Олар операциялар, емдеу немесе зерттеулер кезінде жұғуы мүмкін. •Ең жиі кездесетін аурулар: пневмония, қан тамырларының инфекциялары, зәр шығару жолдарының инфекциялары және тері инфекциялары. •АІИ көбінесе иммундық жүйесі әлсіреген пациенттерде кездеседі, бірақ дұрыс сақтық шараларын қолданбау инфекцияның кез келген адамға жұғуына себеп болуы мүмкін.

#4 слайд
Ауруханаішілік инфекциялардың
жұғу жолдары
Тікелей байланыс арқылы: Есірткілер,
медициналық құралдар, жеке күтім жасау
құралдары арқылы инфекцияның таралуы.
Әуе арқылы: Ауада қозғалатын
микроорганизмдер, мысалы, пневмония
немесе туберкулез инфекциясы.
Қан арқылы: Қан құю кезінде немесе
медициналық құралдарды стерильді емес
қолдану арқылы инфекцияның берілуі.
Сұйықтықтар арқылы: Емдік ерітінділер
немесе дәрі-дәрмектер арқылы инфекцияның
таралуы.
Дененің түрлі бөліктерінен: Операциядан
кейінгі инфекциялар немесе басқа да дене
бөліктерінің ластануы.
4 слайд
Ауруханаішілік инфекциялардың жұғу жолдары Тікелей байланыс арқылы: Есірткілер, медициналық құралдар, жеке күтім жасау құралдары арқылы инфекцияның таралуы. Әуе арқылы: Ауада қозғалатын микроорганизмдер, мысалы, пневмония немесе туберкулез инфекциясы. Қан арқылы: Қан құю кезінде немесе медициналық құралдарды стерильді емес қолдану арқылы инфекцияның берілуі. Сұйықтықтар арқылы: Емдік ерітінділер немесе дәрі-дәрмектер арқылы инфекцияның таралуы. Дененің түрлі бөліктерінен: Операциядан кейінгі инфекциялар немесе басқа да дене бөліктерінің ластануы.

#5 слайд
АІИ жұғуына себепші факторлар
•Медициналық құралдарды дұрыс пайдалану: Инъекциялық құралдарды
немесе катетерлерді дұрыс дезинфекцияламау инфекцияның таралуына себеп
болуы мүмкін.
•Медициналық қызметкерлердің профилактикалық шараларды сақтамауы:
Қолды жуу, қорғаныс құралдарын пайдалану және басқа да сақтық шараларын
елемеу.
•Медициналық мекемелердің санитарлық жағдайы: Емдеу мекемелеріндегі
тазалықтың төмендігі инфекцияның таралуына ықпал етеді.
5 слайд
АІИ жұғуына себепші факторлар •Медициналық құралдарды дұрыс пайдалану: Инъекциялық құралдарды немесе катетерлерді дұрыс дезинфекцияламау инфекцияның таралуына себеп болуы мүмкін. •Медициналық қызметкерлердің профилактикалық шараларды сақтамауы: Қолды жуу, қорғаныс құралдарын пайдалану және басқа да сақтық шараларын елемеу. •Медициналық мекемелердің санитарлық жағдайы: Емдеу мекемелеріндегі тазалықтың төмендігі инфекцияның таралуына ықпал етеді.

#6 слайд
Жұғу жолдары мен
аурулар
•Қан арқылы жұғатын инфекциялар: ВИЧ,
гепатиттер, бактериялық инфекциялар.
•Ауа арқылы жұғатын инфекциялар:
Туберкулез, пневмония, тұмау.
•Жұқпалы жаралар мен тері инфекциялары:
Стафилококк, стрептококк инфекциялары.
•Зәр шығару жолдары арқылы: Зәр
жолдарының инфекциялары (уретрит, цистит).
•Қоршаған орта арқылы: Көбіне
ауруханалардағы ластанған беттер мен
құралдар арқылы жұғады.
6 слайд
Жұғу жолдары мен аурулар •Қан арқылы жұғатын инфекциялар: ВИЧ, гепатиттер, бактериялық инфекциялар. •Ауа арқылы жұғатын инфекциялар: Туберкулез, пневмония, тұмау. •Жұқпалы жаралар мен тері инфекциялары: Стафилококк, стрептококк инфекциялары. •Зәр шығару жолдары арқылы: Зәр жолдарының инфекциялары (уретрит, цистит). •Қоршаған орта арқылы: Көбіне ауруханалардағы ластанған беттер мен құралдар арқылы жұғады.

#7 слайд
Ауруханаішілік инфекциялардың
алдын алу шаралары
•Гигиена және қолды жуу: Медициналық қызметкерлердің қолдарын жиі жууы
инфекцияның таралуын айтарлықтай азайтады.
•Қорғаныс құралдарын пайдалану: Көзілдіріктер, қолғаптар, бетперделер — бұл
құралдар ауруханалық инфекциялардың таралуын болдырмауға көмектеседі.
•Құралдарды стерильдеу: Барлық медициналық құралдарды, әсіресе
инъекциялық және хирургиялық құралдарды дұрыс стерильдеу.
•Санитарлық талаптар: Аурухананың тазалығы мен санитарлық жағдайын сақтау,
барлық бөлмелер мен жабдықтарды дұрыс тазалау.
•Вакцинация: Медициналық қызметкерлерді және пациенттерді белгілі бір
ауруларға қарсы вакцинациялау.
7 слайд
Ауруханаішілік инфекциялардың алдын алу шаралары •Гигиена және қолды жуу: Медициналық қызметкерлердің қолдарын жиі жууы инфекцияның таралуын айтарлықтай азайтады. •Қорғаныс құралдарын пайдалану: Көзілдіріктер, қолғаптар, бетперделер — бұл құралдар ауруханалық инфекциялардың таралуын болдырмауға көмектеседі. •Құралдарды стерильдеу: Барлық медициналық құралдарды, әсіресе инъекциялық және хирургиялық құралдарды дұрыс стерильдеу. •Санитарлық талаптар: Аурухананың тазалығы мен санитарлық жағдайын сақтау, барлық бөлмелер мен жабдықтарды дұрыс тазалау. •Вакцинация: Медициналық қызметкерлерді және пациенттерді белгілі бір ауруларға қарсы вакцинациялау.

#8 слайд
Медициналық қызметкерлердің рөлі:
Медициналық қызметкерлер ауруханаішілік
инфекцияларды болдырмауда маңызды рөл атқарады.
Олар:
Гигиеналық шараларды сақтау;
Қорғаныс құралдарын дұрыс пайдалану;
Инфекцияның алдын алу бойынша науқастарға кеңес
беру;
Жарақаттарды және инфекцияны уақтылы
диагностикалау;
8 слайд
Медициналық қызметкерлердің рөлі: Медициналық қызметкерлер ауруханаішілік инфекцияларды болдырмауда маңызды рөл атқарады. Олар: Гигиеналық шараларды сақтау; Қорғаныс құралдарын дұрыс пайдалану; Инфекцияның алдын алу бойынша науқастарға кеңес беру; Жарақаттарды және инфекцияны уақтылы диагностикалау;

#9 слайд
Пациенттердің рөлі:
•Пациенттер де ауруханаішілік
инфекциялардың алдын алу шараларына
жауапты болуы тиіс:
Тазалықты сақтау, әсіресе жараларды дұрыс
күтіммен өңдеу.
Медициналық қызметкерлерге алдын ала
денсаулық жағдайын хабарлау.
Қорғаныс құралдарын дұрыс пайдалану.
Тек стерильді медициналық құралдармен
емделуге келісу.
9 слайд
Пациенттердің рөлі: •Пациенттер де ауруханаішілік инфекциялардың алдын алу шараларына жауапты болуы тиіс: Тазалықты сақтау, әсіресе жараларды дұрыс күтіммен өңдеу. Медициналық қызметкерлерге алдын ала денсаулық жағдайын хабарлау. Қорғаныс құралдарын дұрыс пайдалану. Тек стерильді медициналық құралдармен емделуге келісу.

#10 слайд
Қорытынды:
•
Ауруханаішілік инфекциялардың жұғуы өте
қауіпті, бірақ оларды алдын алу шараларын
дұрыс жүзеге асыру арқылы болдырмауға
болады.
•
Медициналық мекемелерде жоғары санитарлық
талаптар, гигиеналық нормаларды сақтау және
дұрыс профилактикалық шараларды қолдану
арқылы инфекцияның таралуын айтарлықтай
азайтуға болады.
•
Барлық адамдар — медициналық қызметкерлер
мен пациенттер — ауруханаішілік
инфекцияларды болдырмауға жауапты.
10 слайд
Қорытынды: • Ауруханаішілік инфекциялардың жұғуы өте қауіпті, бірақ оларды алдын алу шараларын дұрыс жүзеге асыру арқылы болдырмауға болады. • Медициналық мекемелерде жоғары санитарлық талаптар, гигиеналық нормаларды сақтау және дұрыс профилактикалық шараларды қолдану арқылы инфекцияның таралуын айтарлықтай азайтуға болады. • Барлық адамдар — медициналық қызметкерлер мен пациенттер — ауруханаішілік инфекцияларды болдырмауға жауапты.

шағым қалдыра аласыз






 Бұл курс Қазақстан Республикасы Оқу-ағарту министрлігімен келісілген
Бұл курс Қазақстан Республикасы Оқу-ағарту министрлігімен келісілген
